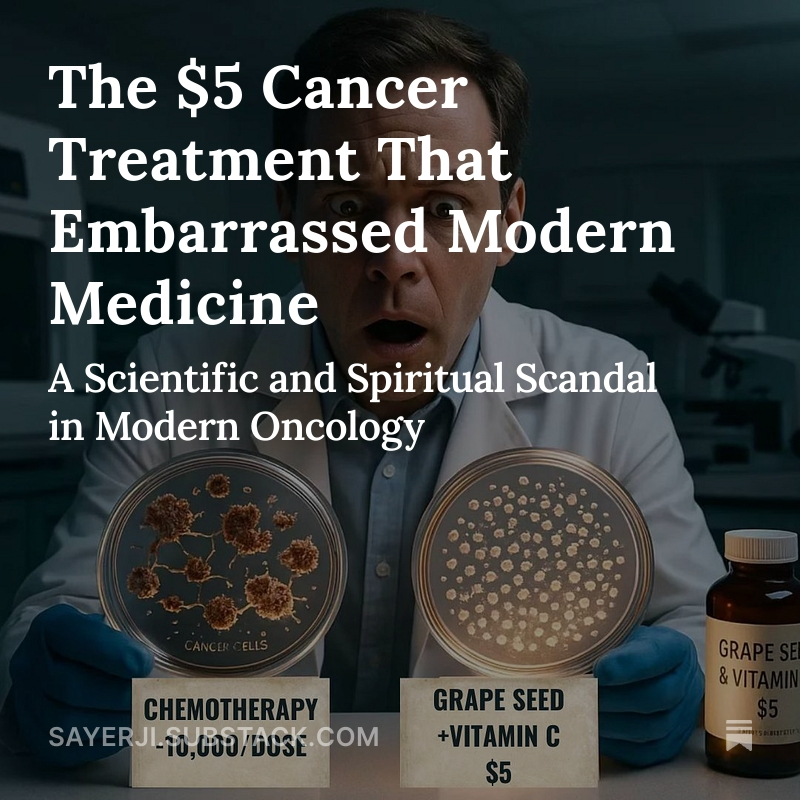

reSee.it - Tweets Saved By @sayerjigmi

@sayerjigmi - Sayer Ji
The US healthcare system kills 440,000+ people annually through medical errors. Another 128,000 die from correctly prescribed drugs. That's 10 Vietnam Wars. Every. Single. Year. Learn more: https://greenmedinfo.com/blog/has-drug-driven-medicine-become-form-human-sacrifice
@sayerjigmi - Sayer Ji
The US healthcare system kills 440,000+ people annually through medical errors. Another 128,000 die from correctly prescribed drugs. That's 10 Vietnam Wars. Every. Single. Year. Learn more: https://greenmedinfo.com/blog/has-drug-driven-medicine-become-form-human-sacrifice https://t.co/uIDHYVeqA6
@sayerjigmi - Sayer Ji
In 2013, the National Cancer Institute admitted millions of "cancers" weren't cancer at all. 1.3 MILLION women unnecessarily treated for breast cancer over 30 years. The medical establishment's response? Crickets 🦗 Learn More: https://greenmedinfo.com/blog/30-years-breast-screening-13-million-wrongly-treated https://t.co/kMttoTSbtU
@sayerjigmi - Sayer Ji
Meanwhile, peer-reviewed studies show: ✅Herniated discs spontaneously disappear ✅Gallstones rarely need surgery ✅Ear infections heal without antibiotics ✅Light therapy beats acne drugs ✅Breathing techniques match antidepressants Your body knows how to heal. Even some cases of breast cancer can regress spontaneously. Learn more: https://greenmedinfo.com/blog/yes-breast-cancer-can-and-often-does-spontaneously-regress-confirmed-case-reports1
@sayerjigmi - Sayer Ji
The cancer industry generates $156 BILLION annually. Every mammogram → biopsy → surgery cascade = $73,200 Watchful waiting = $0 When doing nothing pays nothing, guess what they recommend? Learn more about the dark side of BCAM: https://greenmedinfo.com/blog/covering-causes-breast-cancer-1985-astrazenecas-bcam-2 https://t.co/MW3DEQ1ARt
@sayerjigmi - Sayer Ji
Your body is a 50-trillion-cell quantum symphony that's been perfecting itself for 3.8 billion years. Maybe—just maybe—it knows more about healing than a system that profits from disease. Read the full paradigm-shifting piece: https://sayerji.substack.com/p/do-nothing-the-peer-reviewed-prescription https://t.co/4UElg9GXmA
@sayerjigmi - Sayer Ji
NOT TO BE OVERLOOKED: The Vaccine Schedule 💉 The most unacknowledged cause of medical harm? Vaccination—especially the COVID-19 shots. • 35,000+ reported post-jab deaths (VAERS, a passive system with ~1% capture rate—i.e., the true death toll could be up to 100x higher) • 2+ million injuries • 40% rise in all-cause mortality (2021–) • Zero liability for manufacturers • Mandated. Experimental. Untested long-term. And it didn’t end with COVID. Kids now get 72 shots by 18. Chronic illness is normalized. Sometimes, the most radical health act is refusal. Your body is not a pharmaceutical deficiency. DO NOTHING. It might save your life. We wanted the public in 2020 that the mRNA jabs had deadly side effects before they were widely deployed. Learn more: https://greenmedinfo.com/blog/covid-19-vaccine-bombshell-fda-documents-reveal-death-21-serious-conditions-possi1
@sayerjigmi - Sayer Ji
@drsircus Do you read my articles or just criticize them?

@sayerjigmi - Sayer Ji
🚨 1/BREAKING: Secretary Clinton just told the House Oversight Committee under oath: "I do not recall ever encountering Mr. Epstein." The Epstein files tell a very different story. Here's what the documents actually show. 🧵👇 https://t.co/Pyrc3exFQk

@sayerjigmi - Sayer Ji
🚨The real finding isn't that Gates engineered pandemics for profit. It's simpler — and more troubling. Global health governance: who declares emergencies, who procures vaccines, who controls the surveillance networks — was shaped by unelected private actors, through vehicles designed to avoid transparency, with a convicted sex offender as central intermediary. Project Molecule: five layers of private governance. No parliamentary oversight. No FOIA. Designed to operate "permanently, privately, and across sovereign borders." [Part 2 in my 7-part series: https://sayerji.substack.com/p/inside-project-molecule-how-jpmorgan] You don't need to believe in conspiracy to find this alarming. Convergent incentives with no accountability is its own kind of problem. Same remedy either way: democratic oversight and structural transparency in global health. That's the argument that survives when everything speculative is stripped away. It's consequential enough to stand on its own. 👇 [And yes, that's a real picture of Bill Gates posted by the UN on 2011 to their website]

@sayerjigmi - Sayer Ji
This article took 5 years to write. It may be the most important thing I’ve ever published. The evidentiary chain documented within has profound implications for national security, the viability of our Constitution, and the current US-UK special relationship. I believe congressional investigators, diplomatic channels, and lawmakers on both sides of the Atlantic will want to apprise themselves of this information. One thing is certain: if it weren’t for the coordinated effort to destroy our voices, @SecKennedy would not be a cabinet member today. That campaign backfired — catastrophically — and this is the moment of full revelation. The international censorship apparatus has every reason to keep you from reading this. Please don’t let them win. Read and share widely. 👉 https://sayerji.substack.com/p/the-real-pandemic-profiteers

@sayerjigmi - Sayer Ji
🚨 I've spent weeks inside the Epstein files — not looking for names, but for infrastructure. What I found: Jeffrey Epstein wasn't just a sex trafficker. He was a switchboard — routing government secrets, Wall Street intelligence, and political power through one network. The same network that built the censorship machine that targeted your speech during COVID. Five parts. All sourced to DOJ documents. Here's the whole investigation 🧵👇

@sayerjigmi - Sayer Ji
1/🚨On March 20, 2015, Jeffrey Epstein received a draft agenda for a meeting titled "Preparing for Pandemics." The meeting would feature the Director General of the WHO and the President of the Red Cross. Two weeks later, Bill Gates gave his famous TED talk: "The Next Outbreak? We're Not Ready." The planning documents went through Epstein first. Thread 🧵👇

@sayerjigmi - Sayer Ji
1/🚨 What if the most effective cough treatment on Earth costs $0.50 and sits in your kitchen right now? A double-blind clinical trial found honey + coffee eliminated persistent cough in one week — outperforming prednisolone by a factor of nearly 5. Here's the study they never told you about 🧵👇
@sayerjigmi - Sayer Ji
2/ The landermark study: Published in the Primary Care Respiratory Journal (Nature Publishing Group), researchers at Baqiyatallah University Hospital ran a rigorous 3-year double-blind RCT on 97 adults suffering from persistent post-infectious cough (PPC) — the kind that lingers for weeks or months after a cold. 🔗Study: https://pmc.ncbi.nlm.nih.gov/articles/PMC6442828/
@sayerjigmi - Sayer Ji
3/ Three groups were tested: → Honey + coffee (a jam-like paste) → Prednisolone (a systemic steroid) → Guaifenesin (standard OTC cough med, as control) Each group dissolved their treatment in warm water and drank it every 8 hours for one week.
@sayerjigmi - Sayer Ji
4/ The results were stunning. Honey + coffee: Cough score dropped from 2.9 → 0.2 (p<0.001) Prednisolone: 3.0 → 2.4 (p<0.05) Guaifenesin (control): 2.8 → 2.7 (not significant) The honey-coffee group saw a 93% reduction in cough severity. The steroid? Just 20%. https://t.co/JN9NeRK9Rv
@sayerjigmi - Sayer Ji
5/ Let that sink in. The $0.50 kitchen remedy virtually eliminated the cough. The pharmaceutical steroid barely moved the needle. And the standard OTC cough medicine? Statistically useless. https://t.co/s25weOa70q
@sayerjigmi - Sayer Ji
6/ Now let's talk about the "side effects" of each approach. ❌Prednisolone: fluid retention, high blood pressure, blood sugar spikes, mood swings, insomnia, weight gain, weakened bones, suppressed immunity, adrenal dysfunction, and increased infection risk. For a cough.
@sayerjigmi - Sayer Ji
7/ The "side effects" of honey + coffee? Honey: antimicrobial, antioxidant, anti-inflammatory, promotes tissue healing, WHO-recognized demulcent for respiratory conditions. Coffee: natural bronchodilator (contains methylxanthines like theophylline), anti-inflammatory, hypoalgesic. These aren't side effects. They're side BENEFITS. View the full set of therapeutic properties of honey here: https://greenmedinfo.com/substance/honey And coffee here: https://greenmedinfo.com/substance/coffee
@sayerjigmi - Sayer Ji
8/ Why does this combination work so powerfully? Honey soothes and coats the irritated pharyngeal mucosa, stimulates mucociliary clearance, lowers prostaglandin synthesis, and increases nitric oxide — accelerating tissue repair. Coffee opens the airways and reduces inflammation at the source. Together: synergistic healing.
@sayerjigmi - Sayer Ji
9/ This study was published in 2013. Over a decade ago. How many millions of people have been prescribed steroids, narcotics, codeine, and antihistamines for persistent cough since then — when two items from their kitchen pantry could have done more? People need access to the science of natural healing. That's why we have over 100,000 peer-reviewed studies across 10,000 health topics indexed for you on http://Greenmedinfo.com. It took us 20 years, so it will only take you seconds to find what you are searching for!
@sayerjigmi - Sayer Ji
10/ This is the pattern we see again and again: Nature provides elegant, effective, low-cost solutions that outperform pharmaceutical interventions — and the medical establishment either ignores or suppresses the evidence. The research exists. It's peer-reviewed. It's published in mainstream journals. It just isn't profitable.💰
@sayerjigmi - Sayer Ji
11/ The recipe from the study: A paste made from honey and instant coffee, dissolved in warm water, taken 3x daily for 7 days. No prescription needed. No pharmacy visit. No side effects to manage. Just food as medicine — exactly as nature intended. https://t.co/c7fQEu6gdF
@sayerjigmi - Sayer Ji
12/ Read my full breakdown — including the deeper science, the mechanisms, and what this means for the food-as-medicine movement — in my latest article: A Spoonful of Honey and Coffee Did What Prednisone Couldn’t: Eliminated Persistent Cough in One Week https://sayerji.substack.com/p/a-spoonful-of-honey-and-coffee-did If you found this valuable, please repost the first tweet. This is the kind of research that deserves to reach every household.

@sayerjigmi - Sayer Ji
1/🚨 The DOJ just released thousands of pages of Epstein files. And buried inside them may be one of the biggest bombshells no one is talking about: The blueprint for a 20-year financial architecture designed to turn pandemics into a profit center. Offshore vaccine funds. Pandemic reinsurance triggers. Donor-advised fund structures designed to profit under the cover of charity. Simulation programs. Career pipelines into pharma and the World Economic Forum. All built years before COVID-19. All running through Gates, JPMorgan, and Epstein. We now have the documents. 🧵👇

@sayerjigmi - Sayer Ji
1/ 🚨 Ever wonder how a "pandemic response" worth hundreds of billions appeared fully formed in 2020 — with the vaccines, the surveillance, the financing, the governance all ready to go? Buried in the Epstein files is a 14-page JPMorgan collaborative proposal with the Gates Foundation called PROJECT MOLECULE. ‼️It proposed a permanent, privately governed, transnational vehicle — linking the Gates Foundation, offshore entities, billionaire committees, and $150 million in biological interventions: vaccines, surveillance networks, and disease eradication campaigns across sovereign nations. Not leaked. Disclosed under federal legal process. Three sets of Bates stamps. In Part I, I showed you the emails — Epstein coaching JPMorgan and Gates on the design. Today I'll show you what those emails produced. Here's what they built — and who was at the table. 🧵👇

@sayerjigmi - Sayer Ji
🧵 What if the foundational premise of modern medicine is incomplete? What if you're not primarily being "infected" by viruses, but rather responding to chemical exposures? And what if your body's healing response—the one we call "disease"—is actually being misinterpreted as symptoms of viral infection? Let me show you the evidence.👇
@sayerjigmi - Sayer Ji
2/ It starts with a simple question: If a painkiller damages only your liver, how does your heart rate become irregular, your breathing shallow, your fever spike within hours? The textbook answer: "The drug circulates and affects multiple organs." But the real answer changes everything.
@sayerjigmi - Sayer Ji
3/ What if your body isn't being invaded by a pathogenic enemy? What if it's *signaling*. Your liver suffers chemical damage. Your body releases microscopic particles called exosomes—cellular messengers that carry information to coordinate a whole-body healing response. You feel sick. Medicine calls it infection. 👉This is EXACTLY what a landmark 2018 study found about Tylenol-induced exosome formation which exhibited highly destructive, contagion-like behavior: https://sayerji.substack.com/p/reframing-viral-mechanisms-exosomes?utm_source=publication-search

@sayerjigmi - Sayer Ji
4/Here's the heresy: Viruses and exosomes are molecularly indistinguishable. They share identical marker proteins. They carry the same genetic information. They're the same size. Under electron microscopy, you cannot tell them apart. We've been confusing your body's healing signals for pathogenic invaders.
@sayerjigmi - Sayer Ji
5/ The 2015 influenza virion architecture study proved this. For the first time ever, researchers fully characterized what a "flu virus" actually contains. Result: It's 50% host cell proteins and 50% viral components. The virus isn't "other." It's a hybrid of self and non-self. 👉Dive deeper by reading: Why Everything You Learned About Viruses is WRONG: https://greenmedinfo.com/blog/why-only-thing-influenza-may-kill-germ-theory

@sayerjigmi - Sayer Ji
6/ So what exactly is a virus? A piece of genetic information wrapped in your own cellular machinery. A signal. Not a predator. Not an invader. A *message*. And we built our entire public health system on misreading it.
@sayerjigmi - Sayer Ji
7/ During COVID, this catastrophic confusion became undeniable. PCR tests were designed to detect "viral RNA." But they were amplifying exosomal RNA—your own immune system's response particles. A 2024 peer-reviewed study found: "PCR tests have zero specificity in vivo due to exosome RNA." 👉Dive deeper: PCR Testing Unmasked: The Illusion of Viral Detection in a Sea of Nucleic Acids. https://greenmedinfo.com/content/pcr-testing-unmasked-illusion-viral-detection-sea-nucleic-acids

@sayerjigmi - Sayer Ji
8/ The second and subsequent COVID waves? Largely false positives. Artifacts of a diagnostic technology that couldn't distinguish between your body's healing response and a pathogenic invader. We locked down civilization based on this confusion. 👉Dive deeper: Fool Me Twice? PCR Testing, Covid Hysteria 2.0, and the Looming Avian Flu Pandemic https://greenmedinfo.com/content/fool-me-twice-pcr-testing-covid-hysteria-20-and-looming-avian-flu-pandemic

@sayerjigmi - Sayer Ji
9/But here's what they haven't told you about exosomes: Grape exosomes stimulate intestinal stem cell regeneration. They protect against inflammation. They deliver microRNA instructions that repair damaged tissue. Your body's "infection response" is *literally a healing mechanism*. This isn't metaphorical. Plant-derived exosomes (from grapes) work so effectively that mice treated with them survived *twice as long* when exposed to colitis-inducing toxins. Your body isn't fighting an infection. It's executing a repair protocol. 👉Dive deeper: https://greenmedinfo.com/content/grape-exosomes-natures-nanoparticles-cellular-communication-and-regenerative-h

@sayerjigmi - Sayer Ji
10/ The pharmaceutical industry knows this. But an industry built on treating "infections" with drugs can't profit from understanding that most "illness" is actually the body's successful healing attempt. So the contagion narrative persists. It sells vaccines. It justifies mandates. It generates fear. Instead, there are thousands of natural remedies which focus on providing nutrigenomically rich, miRNA saturated healing substances, which http://GreenMedInfo.com has been indexing for almost two decades: http://www.Greenmedinfo.com


@sayerjigmi - Sayer Ji
11/ What if we reframed the entire paradigm? Not: "You're infected and must be saved." But: "You've been exposed to chemicals that triggered a healing response. Support that response instead of suppressing it." This isn't "anti-science." It's *following the science* to its actual conclusion—the one the institutional medicine establishment refuses to acknowledge because it dismantles their business model.
@sayerjigmi - Sayer Ji
12/ Your fever isn't the enemy. It's your body raising temperature to activate immune signaling. Your cough isn't pathology. It's your body clearing irritated tissue. Your inflammation isn't infection. It's your body's exosomal healing cascade in action.
@sayerjigmi - Sayer Ji
13/ We've pathologized wellness. We've criminalized immunity. We've built an empire on misidentifying our body's most sophisticated self-repair mechanism as an invading enemy that must be destroyed with drugs and vaccines.
@sayerjigmi - Sayer Ji
14/ The real question: What toxins triggered your immune response in the first place? That's what we should be investigating. That's where prevention actually lives. Not in vaccines against viral phantoms. But in removing the chemical poisons that activated the cascade.
@sayerjigmi - Sayer Ji
15/ "Poisoned, Not Infected" isn't just a reframing. It's an indictment of an entire medical paradigm built on fundamental misunderstanding—one that profits from your fear of germs while ignoring the chemicals destroying your cells. ♦️Read the full investigation into how exosomes, chemicals, and institutional denial have created the modern contagion illusion. The science is there. The evidence is undeniable. The only question is whether medicine will ever acknowledge what it's been missing. 👉Read and share the full article: https://sayerji.substack.com/p/poisoned-not-infected-why-your-bodys


@sayerjigmi - Sayer Ji
🔥 BREAKING: Trump is about to DEPORT the British censorship czar who tried to silence RFK Jr. @RobertKennedyJr, Elon Musk @elonmusk, and me. Imran Ahmed spent 4 years labeling Americans "disinformation" and pressuring Big Tech to ban us. The Constitution is back. And it's not negotiable. 🇺🇸⚡ Thread 🧵👇
@sayerjigmi - Sayer Ji
1/ Remember the "Disinformation Dozen"? In 2021, CCDH labeled 12 Americans—including RFK Jr., myself, and others—as targets for deplatforming. They pressured Big Tech to silence us for questioning vaccines, challenging pharma narratives, and spreading MISSING Information. One of us is now Health Secretary. The rest of us? Still fighting. ⚔️ @SecKennedy @DrBenTapper1 @unhealthytruth @BusyDrT @DrChrisNorthrup @RizzaIslam @TTAVOfficial @kellybroganmd @kevinjenkins @mercola
@sayerjigmi - Sayer Ji
2/ Imran Ahmed isn't just some "fact-checker." CCDH was co-founded by Morgan McSweeney—now chief of staff to UK Prime Minister Keir Starmer. This is a POLITICAL operation masquerading as "digital safety," with direct lines to UK Labour leadership. Foreign interference? You tell me. 🇬🇧➡️🇺🇸 More details: https://sayerji.substack.com/p/morgan-mcsweeney-the-british-political

@sayerjigmi - Sayer Ji
3/ CCDH bragged about being "instrumental" in passing the UK's Online Safety Act—a law that empowers government censorship. Now they're exporting that model to America. Last month, UK regulators fined 4chan for content that's LEGAL under the First Amendment. Britain is trying to police American speech. 🚫
@sayerjigmi - Sayer Ji
4/The White House is done playing games. According to The Telegraph and The Spectator, Trump is "waging war on the great British disinformation complex." Revoking Ahmed's visa sends a clear message: Foreign actors will NOT dictate what Americans can say online. This is First Amendment defense. 🇺🇸
@sayerjigmi - Sayer Ji
5/ This isn't just about one deportation. It's about WHO controls speech in America: Unelected foreign NGOs? Tech platforms pressured by UK operatives? Or WE THE PEOPLE through open discourse? For 4 years, they operated with impunity, even setting a "black ops" on then, presidential candidate @RobertKennedyJr . That era is over. ⚖️
@sayerjigmi - Sayer Ji
6/ Imran Ahmed is a defendant in our federal civil rights lawsuit—alongside EVERY entity that colluded to censor Americans. We're holding accountable government agencies, tech platforms, and the entire apparatus. Support the fight to restore constitutional governance: https://sayerji.substack.com/p/on-trial-for-truth-replay-of-live Track our ongoing lawsuit here: https://www.courtlistener.com/docket/70274698/parties/finn-v-global-engagement-center/ The Republic needs you. 🔥 PLEASE SHARE THIS.


@sayerjigmi - Sayer Ji
READ THE FULL STORY HERE: https://open.substack.com/pub/sayerji/p/breaking-trump-admin-to-deport-ccdh?r=x6go&utm_campaign=post&utm_medium=web&showWelcomeOnShare=true


@sayerjigmi - Sayer Ji
1/🧵A jaw-dropping 2012 study achieved 100% diabetes prevention with turmeric. Not a single patient progressed to diabetes. Zero. Meanwhile, metformin—the gold standard drug—managed only 31%. This should have been front-page news. Instead, it was buried. Here's why 👇
@sayerjigmi - Sayer Ji
2/ The Study: 240 prediabetic patients in Thailand. Half got curcumin extract (from turmeric), half got placebo. Results after 9 months: 🔶Curcumin group: 0% developed diabetes 🔶Placebo group: 16.4% developed diabetes 🔶Plus: Improved insulin function, reduced inflammation, virtually no side effects. Published in Diabetes Care—the American Diabetes Association's own journal. 🔗https://diabetesjournals.org/care/article/35/11/2121/30921/Curcumin-Extract-for-Prevention-of-Type-2-Diabetes
@sayerjigmi - Sayer Ji
3/💊 The Pharma Comparison: 🔶Metformin: 31% prevention rate, frequent GI issues, B12 deficiency 🔶Statins (prescribed to millions): Actually raise diabetes risk by 48% in postmenopausal women + 350+ documented side effects 🔶Curcumin: 100% prevention, minimal side effects, costs pennies Which one makes headlines?
@sayerjigmi - Sayer Ji
4/Nature's Arsenal: GreenMedInfo's database: 2,600+ studies on natural diabetes interventions Top performers that rival or beat drugs: 🔶Berberine – Matches metformin's glucose control 🔶Vitamin D – Improves HbA1c levels 🔶Bitter Melon – Outperformed Avandia in trials 🔶Magnesium – Reduces blood sugar AND blood pressure 🔶Probiotics – Heals gut-diabetes connection 🌿608 natural substances with anti-diabetic effects. 🔗DIVE INTO THE WEALTH OF RESEARCH HERE: https://greenmedinfo.com/disease/diabetes-mellitus-type-2

@sayerjigmi - Sayer Ji
5/💰The Economic Truth: Natural compounds can't be patented = no billion-dollar profits The result: 🔶No pharma funding for trials 🔶No TV ads educating doctors 🔶FDA supplement makers from citing their own research 🔶Medical schools don't teach it A cheap spice outperformed metformin, but you'll never see it advertised. 🔗DIVE DEEPER INTO THE RESEARCH ON TURMERIC: https://greenmedinfo.com/substance/turmeric

@sayerjigmi - Sayer Ji
6/The Human Cost: 400+ million people suffer from type 2 diabetes worldwide Standard care = lifelong medication management, not cure What if we prioritized: 🔶Dietary interventions 🔶Herbal compounds 🔶Lifestyle medicine 🔶 Root-cause solutions The potential lives saved and dollars saved? Staggering. 🔗DIVE DEEP INTO HUNDREDS OF TYPE 2 DIABETES SOLUTIONS: https://greenmedinfo.com/disease/diabetes-mellitus-type-2

@sayerjigmi - Sayer Ji
7/The Call to Action: This isn't "alternative" medicine—it's evidence-based medicine suppressed by economic interests. We need: ✓ Public awareness campaigns ✓ Research funding for natural therapies ✓ Regulatory reform ✓ Medical education overhaul Share this thread. Diabetes is preventable, fully reversible. Full article: https://sayerji.substack.com/p/100-diabetes-prevention-achieved @G_W_Forum @standforhealth1 @greenmedinfo @RenzTom @dr_edwardgroup @itsmarlamaples

@sayerjigmi - Sayer Ji
@annvandersteel Right? Amazing

@sayerjigmi - Sayer Ji
1/🚨 The Measles Question Nobody's Asking: Wild Virus or Vaccine Strain?" The media says measles outbreaks are caused by dangerous "anti-vaxxers." But here's what they're NOT telling you: Without genetic sequencing, we literally can't tell if a positive measles test is from wild virus or the MMR vaccine itself. Let me explain... 🧵
@sayerjigmi - Sayer Ji
2/7 VACCINE-ASSOCIATED MEASLES (VAM) IS REAL It's rare but documented in peer-reviewed literature: VACCINE-ASSOCIATED MEASLES (VAM) IS REAL It's rare but documented in peer-reviewed literature: ♦️13-month-old boy in Oklahoma: fever, cough, full-body rash 9 days post-MMR ♦️Measles IgM & RNA confirmed positive ♦️No wild-type measles reported in Oklahoma at the time ♦️Highly suspected vaccine-associated measles In Canada, a 2-year-old was initially counted in an outbreak—then confirmed vaccine-strain after genetic testing. 📕Learn more about this case: https://sayerji.substack.com/p/confirmed-mmr-strain-measles-a-real

@sayerjigmi - Sayer Ji
3/7 THE TESTING GAP NOBODY TALKS ABOUT Standard PCR tests confirm measles infection ✅ But they DON'T tell you which strain ❌ Only genetic sequencing can distinguish vaccine-strain from wild-type. The CDC openly admits: "Vaccine reactions may be mistakenly classified as measles cases." Yet sequencing is RARELY done. [Routine measles genotyping is often limited to a subset of cases, with U.S. coverage as low as 31% in early 2025 and ~54% during 2018–2019; globally, reported sequences represent a tiny fraction of estimated cases: ~ 1% or less.]
@sayerjigmi - Sayer Ji
4/7 VIRAL SHEDDING: THE INCONVENIENT TRUTH A 2024 study found measles vaccine RNA in 33% of children up to 4 weeks post-MMR. The vaccine virus is replicating in their respiratory tract. Can it spread? The CDC says "no evidence of transmission." But are we actually looking? Or just assuming? 📕Source: https://pubmed.ncbi.nlm.nih.gov/38823291/

@sayerjigmi - Sayer Ji
5/7 CASE STUDY: TEXAS 2025 Over 200 measles cases reported after mass vaccination campaign launched. ♦️Some cases in FULLY VACCINATED individuals ♦️Largest spike came AFTER the vaccine push ♦️Officials didn't disclose how many were recently vaccinated ♦️NO genotyping data released Coincidence? 📕Texas outbreak data: https://www.dshs.texas.gov/news-alerts/measles-outbreak-2025
@sayerjigmi - Sayer Ji
6/7 THE RISK-BENEFIT REALITY CHECK Pre-vaccine death/disability rate from measles, mumps & rubella COMBINED: 1 in 500,000 for healthy children. MMR trials: Only a few thousand subjects—not nearly enough to prove safety. Measles death rates plummeted BEFORE the vaccine, due to nutrition & sanitation. Learn more by reading: https://www.amazon.com/Dissolving-Illusions-Disease-Vaccines-Forgotten/dp/1480216895 @DrSuzanneH7 @RBystrianyk

@sayerjigmi - Sayer Ji
7/7 "INFORMED CONSENT IS BACK" — Acting CDC Director Jim O'Neill, 2025 It's time to: ✅ Genotype ALL measles cases ✅ Disclose vaccine-strain detections Transparency doesn't erode trust—SECRECY does. Read the full investigation: https://sayerji.substack.com/p/wild-type-or-vaccine-strain-investigating


@sayerjigmi - Sayer Ji
🧬 BREAKING: A 1993 study revealed something extraordinary that medicine forgot about— Vitamin C can literally REGENERATE damaged steroid hormones (progesterone, testosterone, estrogen) by donating electrons to repair their molecular structure. Up to 91% hormone restoration was achieved. 🧵
@sayerjigmi - Sayer Ji
2/7📚 THE STUDY: "Photo-induced regeneration of hormones by electron transfer processes" by Dr. Nikola Getoff et al., published in Radiation Physics and Chemistry (1993) They exposed hormones to UV damage, then added vitamin C—which successfully regenerated 53-91% of broken hormone molecules. 👉https://www.researchgate.net/publication/51545130_Photo-induced_regeneration_of_hormones_by_electron_transfer_processes_Potential_biological_and_medical_consequences
@sayerjigmi - Sayer Ji
3/7🛡️ CANCER PREVENTION ANGLE: When hormones break down improperly, they form metabolites that can damage DNA and trigger cancer. By regenerating hormones BEFORE they degrade, vitamin C prevents formation of these "potentially carcinogenic metabolites." A whole new approach to prevention.
@sayerjigmi - Sayer Ji
4/7 IMPLICATIONS FOR HRT: Instead of just adding external hormones, what if we could PRESERVE and REPAIR our body's own hormones? Vitamin C may offer a safer complement (or alternative) to conventional hormone replacement therapy—with virtually no side effects at normal doses.
@sayerjigmi - Sayer Ji
5/7🔬 SZENT-GYÖRGYI'S INSIGHT (Nobel Prize 1937): The scientist who discovered vitamin C noted something profound: His colleague was CURED using paprika (whole food vitamin C), but the same effect FAILED with isolated ascorbic acid. Whole foods contain synergistic flavonoids—"vitamin P."
@sayerjigmi - Sayer Ji
6/7 💡 THE PARADIGM SHIFT: We're not at the mercy of declining hormones as we age. Vitamin C shows us that nutritional medicine can actively REPAIR and RESTORE—not just prevent disease. Sometimes the most profound solutions are hiding in plain sight. Full article: https://sayerji.substack.com/p/resurrecting-youth-the-1993-discovery


@sayerjigmi - Sayer Ji
🧵Legacy Gatekeeper Nature/Springer just came for Substack’s jugular… Science publishers accuse Substack writers of “profiteering from misinformation” — while standing knee-deep in its own documented scientific fraud. 👇
@sayerjigmi - Sayer Ji
1️⃣Last week, Nature — the flagship journal of “scientific consensus” — sent me and other prominent Substack writes a “request for comment.” (@RWMaloneMD @MaryanneDemasi @sasha_latypova @P_McCulloughMD and others) But it wasn’t journalism. It was a prosecution dressed as inquiry. 🚨A prewritten verdict accusing us of endangering public health and profiting from misinformation.
@sayerjigmi - Sayer Ji
2️⃣Their entire premise hinged on a proven lie — the “Disinformation Dozen” report from the Center for Countering Digital Hate. Meta’s own data blew it apart: those twelve people accounted for 0.05% of vaccine-related content, not 65–73%. A 1,300-fold exaggeration weaponized to erase dissent. 📖 Read the full exposé: 👉 https://sayerji.substack.com/p/springer-natures-glass-house-the

@sayerjigmi - Sayer Ji
3️⃣ So when Nature asked for comment, it wasn’t seeking truth — it was serving notice. Every sentence read like a charge sheet. Every question carried the weight of accusation. ⚖️ 🚨But here’s the twist: A 2025 PNAS study found Nature’s parent company, Springer Nature, is one of the world’s largest publishers of industrial-scale scientific fraud.💥 The numbers are staggering: 🔹 Springer Nature — 16.2% of fraudulent papers 🔹 Wiley — 11.2% 🔹 Elsevier — 9.7% That’s right: the empire pointing its finger at Substack hosts more fake science than anyone. (Source: https://www.pnas.org/doi/10.1073/pnas.2420092122)
@sayerjigmi - Sayer Ji
4⃣In the study’s own words: “Large North American and European publishers and the editors they appoint provide credibility to these practices.” Translation: the gatekeepers became the enablers. So when they accuse independent journalists of “profiteering,” remember who profits most — the corporations monetizing fake data under the banner of peer review. 💰 This isn’t just about hypocrisy. It’s about power — and the rise of a new Fifth Estate: the networked journalists, scientists, and citizens reclaiming science from institutional rot. 🌍
@sayerjigmi - Sayer Ji
5⃣I’ve spent 17 years building open-access science platforms like GreenMedInfo — indexing over 100,000 peer-reviewed studies. That’s not “misinformation.” That’s transparency — something Nature seems to have misplaced. 👉Use the free resource here: https://greenmedinfo.com/

@sayerjigmi - Sayer Ji
6⃣Now, the same machine that slandered us is being called to account. Our federal civil rights lawsuit in Florida names CCDH, Imran Ahmed, U.S. officials, and major tech platforms for orchestrating a censorship and defamation campaign against U.S. citizens. ⚖️🔥 Support & the fight here: https://sayerji.substack.com/p/on-trial-for-truth-replay-of-live?utm_source=live-stream-redirect&triedRedirect=true Follow the other plaintiffs here: @unhealthytruth @BusyDrT @DrChrisNorthrup @RizzaIslam @DrBenTapper1

@sayerjigmi - Sayer Ji
7⃣As one of our attorneys put it: “We’re up against some of the most powerful law firms on the planet. But the law is on our side — and so is the truth. We can win this, but we can’t do it alone.” If you believe free inquiry is sacred — if you believe science must never serve censorship — then stand with us. 🙏 💥 Read, share, and support the fight for truth: 👉 https://sayerji.substack.com/p/springer-natures-glass-house-the And please support accounts like @VigilantFox, @Inversionism, @RenzTom, @newstart_2024 who are leading the charge with fearless journalism on X and elsewhere!


@sayerjigmi - Sayer Ji
🚨 1/MUST-WATCH: Former YouTube CEO Susan Wojcicki admits they removed over 1 million COVID videos — while coordinating directly with Biden & Fauci. Even more disturbing: she doesn’t just defend the censorship, she pathologizes dissent — musing about whether “anti-vaxxers” should be psychoanalyzed for their behavior. This wasn’t “content moderation.” It was government-directed censorship at mass scale — erasing science, silencing citizens, and rewriting reality.🧵
@sayerjigmi - Sayer Ji
2/ On Sept 23, 2025, Alphabet (Google/YouTube’s parent) finally CONFESSED in writing to @Jim_Jordan: ➡️ The Biden administration pressured them to censor lawful speech. ➡️ They called this pressure “unacceptable and wrong.” 🔥This is the smoking gun.
@sayerjigmi - Sayer Ji
3/ For years, the so-called “Disinformation Dozen” were vilified, deplatformed, and erased . We said this wasn’t about health or misinformation. It was about CONTROL. Alphabet’s admission proves we were right all along.
@sayerjigmi - Sayer Ji
4/ My deep-dive article breaks it all down: 🔎 Alphabet’s confession 🔎 Susan Wojcicki’s chilling brag 🔎 The global censorship-industrial complex 🔎 Why our federal civil rights lawsuit is the road to justice 📖 Read here ➡️ https://sayerji.substack.com/p/breaking-big-tech-admits-censorship

@sayerjigmi - Sayer Ji
5/ This fight is bigger than me. It’s about restoring the First Amendment for EVERY American. No citizen should ever be erased because their views are politically inconvenient. ⚖️ Join us. Share this. Support the lawsuit. The road to accountability starts NOW. Let's do this! Learn more: https://sayerji.substack.com/p/on-trial-for-truth-replay-of-live @DrChrisNorthrup @unhealthytruth @RizzaIslam @DrBenTapper1 @DrChrisNorthrup @mercola @RobertKennedyJr @TTAVOfficial @greenmedinfo @standforhealth1 @G_W_Forum

@sayerjigmi - Sayer Ji
This was the May 2021 meeting where YouTube staged a so-called “Town Hall” with President Biden, Dr. Fauci, and hand-picked influencers. Marketed as “conversation,” it was in truth a state-sanctioned propaganda event: the White House partnered with a private platform that was simultaneously banning dissenting voices, narrowing what Americans could see and hear to only government-approved talking points. This is not free speech — it is viewpoint discrimination directed by the state and enforced by Big Tech. Events like this expose the architecture of a censorship regime where government power merges with corporate control to erase debate under the guise of “public health.” The Constitution forbids the government from outsourcing its censorship to private actors, yet this is exactly what happened. What was presented as outreach was, in fact, an egregious violation of civil liberties — a calculated move in a global campaign to weaponize “disinformation” as a pretext for silencing dissent and manufacturing consent. https://blog.youtube/news-and-events/white-house-youtube-town-hall/?utm_source=chatgpt.com

@sayerjigmi - Sayer Ji
Indeed, these 'researchers' amplified a fake report by CCDH (a UK-US intelligence cutout who laundered civil rights violations on behalf of governments and corporations) which had a 1300 FOLD error, yet it was used by the research community in a dozen or more peer-reviewed and published studies to further crystallize the lies against us: https://greenmedinfo.com/content/disinformation-publication-case-study-academic-failure1


@sayerjigmi - Sayer Ji
🚨 HAPPENING NOW: 48 HOURS before Senate hearing designed to topple RFK Jr. Big Pharma's own meeting minutes from April reveal executives explicitly planned to "go to The Hill and lobby that it is time for RFK Jr to go" Thursday's Senate hearing is their coup finale. 🧵👇
@sayerjigmi - Sayer Ji
1⃣The smoking gun: BIO (Big Pharma's lobby) allocated $2 million—HALF their cash reserves—for a campaign against Kennedy just 2 months into his tenure. Why? Kennedy's transparency demands and safety reviews threatened to "render their current profit model obsolete." 💰 Read @lifebiomedguru's @brownstoneinst report on the BIO memo: The Plot to Get RFK https://brownstone.org/articles/the-plot-to-get-rfk/

@sayerjigmi - Sayer Ji
2⃣The coordination is undeniable: ♦️April: BIO plans congressional pressure campaign ♦️August-Sept: Suddenly 1,000+ HHS employees demand resignation ♦️Sept 9: Bernie Sanders holds "Vaccines Work" press conference ♦️Sept 12: Sanders publishes Guardian op-ed calling for RFK's removal
@sayerjigmi - Sayer Ji
3⃣Foreign fingerprints everywhere: ♦️UK-based CCDH planned "black ops" against RFK Jr. since 2024. Their strategic docs identified The Guardian as key platform for narratives. ♦️Sanders' Guardian op-ed wasn't journalism—it was the execution of a foreign influence operation.
@sayerjigmi - Sayer Ji
4⃣Thursday's Senate hearing chair? Senator Cassidy—who BIO specifically identified as an "emerging influential advocate" back in April. The same lobbyists who planned Kennedy's ouster now have their ally holding the gavel. This isn't oversight—it's orchestrated theater.
@sayerjigmi - Sayer Ji
5⃣The witnesses testifying Thursday (ousted former CDC director Susan Monarez, Ph.D., and recently resigned CDC CMO Debra Houry, MD., M.P.H) are the same figures who've been calling for Kennedy's resignation in the coordinated media blitz. RFK Jr. was not invited to participate. No defense witnesses. No fair process. Just a predetermined outcome dressed up as "radical transparency." Hearing link: https://www.help.senate.gov/hearings/restoring-trust-through-radical-transparency-reviewing-recent-events-at-the-centers-for-disease-control-and-prevention-and-implications-for-childrens-health

@sayerjigmi - Sayer Ji
6⃣This is bigger than RFK Jr. This is about whether unelected power brokers can stage-manage the removal of officials who threaten their profits. If they succeed Thursday, any reformer is vulnerable to the same treatment. But MAHA can't be ousted—the movement is unstoppable. Our democracy is not for sale. @MAHA_Action
@sayerjigmi - Sayer Ji
7⃣📖 READ THE FULL EXPOSÉ: https://sayerji.substack.com/p/the-coup-how-big-pharmas-2-million 🇺🇸 TAKE ACTION NOW: Show your support for @SecKennedy today by contacting your Congressmen in ONE EASY STEP below through the health freedom platforms below: 🔹Children's Health Defense: Tell your elected officials you stand with RFK Jr. and MAHA https://childrenshealthdefense.org/community/show-your-support-wear-it-share-it-take-action-and-rally-for-rfk-jr/ @ChildrensHD 🔹 Stand for Health Freedom: Kennedy stood firm—tell your senators you stand with him https://standforhealthfreedom.com/actions/kennedy-firm/ @standforhealth1 Tag, comment, and share this! RT PLEASE! 🚨DIVE DEEP BY READING THE BREAKING EXPOSE: THE COUP: How Big Pharma's $2 Million War Chest Bought This Thursday's Senate Hearing https://sayerji.substack.com/p/the-coup-how-big-pharmas-2-million




@sayerjigmi - Sayer Ji
@SecKennedy @G_W_Forum @RenzTom @standforhealth1 @ChildrensHD Correction: the hearing date is Wednesday, Sept 17th 10:00am: https://www.help.senate.gov/hearings/restoring-trust-through-radical-transparency-reviewing-recent-events-at-the-centers-for-disease-control-and-prevention-and-implications-for-childrens-health


@sayerjigmi - Sayer Ji
🚨 BREAKING: HHS under RFK Jr. is reportedly preparing to officially link Tylenol use during pregnancy to autism - vindicating researchers (and sites like http://GreenMedInfo.com) who've warned about this for DECADES while being dismissed by the medical establishment. Kenvue stock already down 10% 📉

@sayerjigmi - Sayer Ji
1⃣ The science is overwhelming: 46 studies analyzed by Harvard researchers show consistent association between prenatal acetaminophen exposure and neurodevelopmental disorders. ⚠️Every single study examining long-term effects on child brain development found evidence of harm - not one showed it was safe. Source study: 🔗https://ehjournal.biomedcentral.com/articles/10.1186/s12940-025-01208-0

@sayerjigmi - Sayer Ji
2⃣💊 Here's the mechanism: Acetaminophen depletes glutathione - the body's "master antioxidant" - during critical brain development windows. This leaves developing brains vulnerable to oxidative stress when they need protection most -- especially when confronted with an insane vaccine schedule of (70+ vaccines by age 18), loaded with aluminum adjuvants and other toxic compounds. Boys are 3-4x more affected than girls 🧬
@sayerjigmi - Sayer Ji
3⃣Plot twist: Tylenol doesn't just affect autism risk - it literally blunts human empathy and emotions. Studies show people on acetaminophen feel less joy, less empathy, less connection. Imagine the societal impact when 1 in 4 adults take it weekly 💔 🚨Learn more why Tylenol should be banned: https://greenmedinfo.com/blog/consumer-alert-deadly-reason-tylenol-should-be-banned-immediately2

@sayerjigmi - Sayer Ji
4⃣⚖️ The legal reckoning: Thousands of families are suing in federal court. J&J tried every trick to dismiss cases but failed. Judge ruled they COULD have added pregnancy warnings but chose not to. Internal docs show they knew it was never tested for brain safety 📋 Learn more about this case by reading: https://www.reuters.com/legal/litigation/tylenol-adhd-lawsuits-cannot-go-forward-judge-rules-2024-08-20/
@sayerjigmi - Sayer Ji
5⃣ For parents: This doesn't mean panic if you used Tylenol. Risk increases are significant population-wide but modest individually (20-30% relative risk increase). But going forward - treat it like what it is: a real medication with real risks, not candy 🍼 👉Learn about the other toxic effects of Tylenol you won't hear reported elsewhere on the @greenmedinfo database: https://greenmedinfo.com/toxic-ingredient/tylenol 👉Conversely, learn about natural substances that mitigate Tylenol toxicity here: https://greenmedinfo.com/disease/acetaminophen-tylenol-toxicity


@sayerjigmi - Sayer Ji
6⃣🔬 This could be our "thalidomide moment" - forcing a complete rethink of drug safety standards for pregnancy. Autism rates: 1 in 1,000 (1990s) → 1 in 31 today. Time to ask hard questions about what we've been told is "safe" Dive deeper into by reading my latest substack on the topic: Breaking: Government Finally Admits Tylenol-Autism Link After Years of Corporate Cover-Up https://sayerji.substack.com/p/breaking-government-finally-admits Follow me for more:@sayerjigmi📧 Subscribe: http://sayerji.substack.com All links: https://campsite.bio/sayerji (Yes, I'm one of the 2021 'disinformation dozen.' Lost 2M followers. Truth survived anyway.)



@sayerjigmi - Sayer Ji
🚨 BREAKING: The $5 Cancer Treatment That Embarrassed Modern Medicine Animal study published days ago shows grape seed extract + vitamin C achieved 76.6% tumor shrinkage vs. 68.8% for doxorubicin in mice with aggressive cancer.If this translates to humans, Big Pharma has a problem. Here's why they're staying quiet: 🧵
@sayerjigmi - Sayer Ji
1⃣💰 While cancer patients mortgage their homes for $10,000+ treatments with doxorubicin (nicknamed "Red Devil" by nurses for its brutal toxicity), researchers just proved two grocery store supplements might work BETTER. The pharmaceutical industry's worst nightmare: A cure they can't patent, can't monopolize, and can't charge thousands for.
@sayerjigmi - Sayer Ji
2⃣🎯 Here's what has executives panicking: These weren't exotic lab compounds. Grape seed extract and vitamin C - things humans have consumed for millennia - just outgunned one of oncology's most aggressive drugs. And unlike chemo, they didn't destroy the patient in the process.
@sayerjigmi - Sayer Ji
3⃣⚡ The data is explosive: Not only did the natural combo shrink tumors more effectively, it REBUILT the immune system while doing it. T-cells surged 35% into tumors. Cancer-protective cells dropped 26%. The body started fighting back on its own. Link: Full study - Frontiers in Immunology, August 2025: https://www.frontiersin.org/journals/immunology/articles/10.3389/fimmu.2025.1635071/full

@sayerjigmi - Sayer Ji
4⃣🌱 The hypothetical translation to human doses? About 1 gram grape seed extract + 300mg vitamin C daily. Available at any health store for ~$5/month. Compare that to a single doxorubicin session: $3,000+ plus hospital monitoring because it's literally poison. 🔬 This exposes the fundamental fraud of cancer treatment: For 80 years we've accepted "necessary" collateral damage - hair loss, organ failure, immune destruction. What if the gentler approach was actually MORE effective all along? 👉To dive deeper into the therapeutic potential of both grape seed and vitamin C, consult the http://GreenMedInfo.com databases on the subjects here: 🍇Grapeseed: https://greenmedinfo.com/substance/grape-seed-extract 🍊Vitamin C: https://greenmedinfo.com/substance/vitamin-c



@sayerjigmi - Sayer Ji
🚨 If human trials confirm these results, it won't just change cancer treatment - it will expose how many patients suffered needlessly while the answer was sitting on health store shelves. The silence from major medical institutions speaks volumes. 👉Dive deeper by reading my latest substack on the topic here: "The $5 Cancer Treatment That Embarrassed Modern Medicine" https://sayerji.substack.com/p/the-5-cancer-treatment-that-embarrassed


@sayerjigmi - Sayer Ji
🧵 The natural health community in 2025: "Ban artificial food dyes! They're neurotoxic!" 🚫 Also the natural health community: "This 150-year-old petroleum-based textile dye is my favorite brain supplement!" 💙 The cognitive dissonance would be funny if it weren't so dangerous. Methylene blue — yes, the same aniline dye derived from coal tar that our ancestors used to color cloth — has somehow become wellness culture's dirty little secret. Let me show you what's really happening when you swallow that electric blue "nootropic"...👇
@sayerjigmi - Sayer Ji
1⃣Methylene blue (MB) is being marketed as a mitochondrial booster and cognitive enhancer. But here's what they're NOT telling you: ❌It's a petroleum-derived synthetic dye ❌Has an FDA BLACK BOX warning ❌Can trigger fatal serotonin syndrome with antidepressants
@sayerjigmi - Sayer Ji
2⃣Recent human research shows MB actually DECREASES brain blood flow in healthy people. A 2023 study found it: ❌Reduced cerebral blood flow ❌Decreased brain oxygen metabolism ❌Suppressed glucose utilization The opposite of what biohackers claim it does. 📍Source: https://pubmed.ncbi.nlm.nih.gov/36803299/

@sayerjigmi - Sayer Ji
3⃣Methylene blue can harm neurons at relatively low concentrations—but the context matters. Studies show that in neuronal cell experiments (in vitro): ❌ Around 10 µM (≈3.2 µg/mL) can trigger oxidative stress, impair electrical signaling, and cause neurons to lose branches and degenerate. ❌ This is where cells in a dish begin showing measurable toxicity. 👉 What does “damages neurons at 10 µM” mean in plain English? It means that at this concentration, nerve cells start to malfunction, stop communicating properly, and eventually die off in lab experiments. 📏 To give perspective: ❌10 µM = about 0.003 mg per milliliter of fluid. ❌Some MB supplements recommend 0.5–4 mg per dose—but whether that leads to 10 µM levels in the brain depends on absorption, blood-brain barrier penetration, and metabolism. ⚠️ The takeaway: while low-dose MB is often marketed as “brain fuel,” studies remind us that the line between helpful and harmful is thin. Dose, context, and biology matter—and what looks like a nootropic at one level can become a neurotoxin at another. 📍Source: https://journals.sagepub.com/doi/10.1177/17448069221142523
@sayerjigmi - Sayer Ji
4⃣Here's the most disturbing part: ❌Forensic autopsies of patients given MB show their brains turn BLUE-GREEN after death. ❌The dye accumulates in brain tissue and oxidizes postmortem, revealing just how much has lodged in your neurons while alive. Learn more: https://sayerji.substack.com/p/the-blue-brain-effect-methylene-blues?utm_source=publication-search

@sayerjigmi - Sayer Ji
5⃣MB can cause: ❌Hemolytic anemia (in G6PD deficient individuals) ❌Tissue necrosis at injection sites ❌Dangerous blood pressure spikes ❌Heart arrhythmias ❌Oxidative stress (yes, the "antioxidant" becomes a pro-oxidant) The serotonin syndrome risk is REAL. Multiple deaths reported when MB combined with SSRIs/antidepressants. MB acts as an MAOI at higher doses, causing: ❌High fever ❌Muscle rigidity ❌Seizures ❌Potentially fatal neurochemical chaos
@sayerjigmi - Sayer Ji
6⃣But here's the good news - nature provides SUPERIOR alternatives: Chlorophyll (green plants): ✅Absorbs same red/NIR wavelengths as MB ✅Actually safe ✅True antioxidant ✅Enhances mitochondrial ATP production
@sayerjigmi - Sayer Ji
7⃣Phycocyanin (blue spirulina): ✅Nearly identical light absorption to MB (620-640nm) ✅4x safer than MB ✅Crosses blood-brain barrier WITHOUT staining it blue ✅Proven neuroprotective effects ✅No drug interactions
@sayerjigmi - Sayer Ji
8⃣Anthocyanins (berries, butterfly pea): ✅Powerful brain antioxidants ✅Reduce dementia risk ✅Improve memory ✅Combat neuroinflammation ✅~200 benefits indexed on the http://GreenMedInfo.com database: https://greenmedinfo.com/substance/anthocyanins Turn your tea blue naturally (not your brain!)


@sayerjigmi - Sayer Ji
9⃣Better brain stack WITHOUT the industrial dye: Morning: ✅Spirulina + berries smoothie ✅Red light therapy or sunrise exposure ✅CoQ10 + PQQ ✅Lion's Mane + Omega-3s You get photobiomodulation benefits without petroleum derivatives.
@sayerjigmi - Sayer Ji
🔟Bottom line: MB is an emergency antidote being misused as a daily supplement. No long-term safety studies exist for healthy people taking it regularly. If we reject coal tar dyes in food, why accept them in our brains? Choose coherence. Choose nature. See red over methylene blue. 👉Read my substack deep dive on the topic here: Synthetic Blues: When Biohackers Choose Petroleum Over Plants https://sayerji.substack.com/p/synthetic-blues-when-biohackers-choose


@sayerjigmi - Sayer Ji
🔮 BREAKING: What if I told you crystals aren't just "woo-woo" - but actually operate on the same plane as the physics principles that power your smartphone? New research into scalar waves & phase conjugation is validating what shamans knew for millennia. This changes everything 🧵👇
@sayerjigmi - Sayer Ji
1⃣First, let's talk about Tesla. Over 100 years ago, Nikola Tesla discovered "non-Hertzian waves" - longitudinal waves that: ✅Don't diminish with distance ✅Pass through solid matter ✅Travel faster than light (controversial but documented) He called them "radiant energy"
@sayerjigmi - Sayer Ji
2⃣Here's where it gets wild: When two electromagnetic waves cancel each other out perfectly (180° out of phase), the energy doesn't disappear. It converts into a "scalar wave" - a standing wave of pure potential energy. Think noise-canceling headphones, but for reality itself.
@sayerjigmi - Sayer Ji
3⃣Enter crystals 💎 Crystals are nature's phase-conjugate mirrors. Their perfect lattice structure does something remarkable: They take chaotic energy and reflect it back as COHERENT energy - essentially "time-reversing" distorted waves back to their original state.
@sayerjigmi - Sayer Ji
4⃣This isn't pseudoscience. It's used in: ✅Laser technology (optical phase conjugation) ✅Quantum computing (coherence preservation) ✅Your quartz watch (frequency stabilization) The same physics applies to healing - we just haven't admitted it yet.
@sayerjigmi - Sayer Ji
5⃣Dr. Marcel Vogel (IBM scientist, 100+ patents) proved you can "program" crystals with intention. His specially-cut crystals could: ✅Restructure water molecules ✅Store information patterns ✅Amplify biological fields IBM's own scientist. Let that sink in.
@sayerjigmi - Sayer Ji
6⃣But here's the REALLY mind-blowing part: Your body is FULL of crystals: ✅Pineal gland: Calcite microcrystals (piezoelectric) ✅Bones: Hydroxyapatite crystals (generate electricity when stressed) ✅DNA: Helical antenna structure (fractal crystal) You're a walking crystal radio.
@sayerjigmi - Sayer Ji
7⃣In 2002, scientists discovered the pineal gland contains unique, micron-sized calcite crystals that are: ✅Piezoelectric (convert pressure to electricity) ✅Capable of second harmonic generation ✅Potentially sensitive to magnetic fields Your "third eye" is literally a crystal transducer.
@sayerjigmi - Sayer Ji
8⃣ The Hutchison Effect proves this isn't theoretical. Using Tesla coils + crystals, John Hutchison achieved: ✅Levitation of 70-pound objects ✅Metal jellification ✅Crystal batteries producing continuous power for MONTHS The Pentagon classified his research. Wonder why?
@sayerjigmi - Sayer Ji
9⃣Modern healing devices now use this: ✅RASHA: Scalar-plasma crystal harmonizer (FDA registered) ✅Theraphi: Phase-conjugate plasma field generator ✅CyberScan: Tesla coil biofield scanner These aren't "alternative" - they're just ahead of mainstream acceptance. 👉Watch my interview with Paul Harris, co-inventor of the Theraphi here: https://sayerji.substack.com/p/teslas-dream-realized-the-healing

@sayerjigmi - Sayer Ji
🔟Here's what scalar waves can do that regular EM waves can't: ✅Pass through Faraday cages ✅Create non-local effects (distance irrelevant) ✅Carry information without force Interface directly with consciousness This explains "impossible" healing phenomena.
@sayerjigmi - Sayer Ji
1⃣1⃣The prayer position (hands together) creates a biological phase-conjugate mirror. Left hand = one wave Right hand = opposite phase wave Together = scalar field generation Brain scans show unique coherence patterns when people pray. Coincidence? ✨Learn more about this incredible effect by reading my recent article: https://sayerji.substack.com/p/your-bodys-hidden-technology-the

@sayerjigmi - Sayer Ji
1⃣2⃣Dr. Konstantin Meyl showed DNA acts as a scalar wave antenna: ✅Transmits at MHz frequencies ✅Synchronized with biophotons ✅Enables cell-to-cell communication ✅Responds to consciousness/intention Your thoughts literally broadcast through your DNA.
@sayerjigmi - Sayer Ji
1⃣3⃣We're not talking about replacing medicine. We're talking about understanding the BIOPHYSICS of why: ✅Intention affects matter ✅Distance healing works ✅Crystals amplify effects ✅Consciousness isn't confined to the brain The science is catching up to the mystics.
@sayerjigmi - Sayer Ji
1⃣4⃣The bridge between science and spirit isn't being built - it's being REVEALED. ✅Crystals are just the beginning. ✅Full deep dive here: https://sayerji.substack.com/p/crystal-healing-new-age-hoax-or-leading If you found this mind-expanding, RT the first tweet. It's time to end the false divide between physics and metaphysics. 🔮⚡

@sayerjigmi - Sayer Ji
@leadfreeH2OinDC 🤣

@sayerjigmi - Sayer Ji
The true cost of the mRNA jab campaigns is only now being honestly accounted for by those few fearless enough to tell the truth. @DowdEdward @BretWeinstein https://t.co/z94W2sWZm5

@sayerjigmi - Sayer Ji
🚨 Scientists just discovered you have a SECOND HEART in your calf. It's called the soleus muscle—just 1% of your body weight—but if it fails, you're 4X more likely to die. The craziest part? You can activate it while sitting at your desk. Here's what you need to know🧵
@sayerjigmi - Sayer Ji
Your soleus muscle is a metabolic furnace that NEVER stops working: ✅Slashes blood sugar spikes by 52% ✅Cuts insulin needs by 60% ✅Burns fat for HOURS without fatigue ✅Pumps blood with 200mmHg pressure (higher than your blood pressure!) All from a muscle most doctors ignore.
@sayerjigmi - Sayer Ji
Why is this "second heart" so powerful? Unlike other muscles that burn out quickly, your soleus: ✅Has 87% slow-twitch fibers (like marathon runners) ✅Contains blood-storage pockets that squeeze blood upward ✅Burns blood sugar WITHOUT depleting its energy stores It's literally built different.
@sayerjigmi - Sayer Ji
The Mayo Clinic studied 2,728 patients. Those with weak calf pumps had 8.9% mortality at 5 years. Those with strong calf pumps? Just 2.4%. That's nearly 4X higher death risk from ignoring one muscle. Yet 90% of people let their soleus "go to sleep" from too much sitting.
@sayerjigmi - Sayer Ji
Post 5: The fix is stupidly simple: "Soleus Push-Ups" While seated: 1⃣Keep feet flat, lift heels 2⃣Lower slowly 3⃣Repeat 40-60x/min But there's SO much more to this discovery... Read the full mind-blowing research here: https://sayerji.substack.com/p/the-second-heart-you-never-knew-you


@sayerjigmi - Sayer Ji
DO NOTHING. That's it. That's the most radical medical advice of our time. A thread on why avoiding healthcare might be your best health decision 🧵
@sayerjigmi - Sayer Ji
The US healthcare system kills 440,000+ people annually through medical errors. Another 128,000 die from correctly prescribed drugs. That's 10 Vietnam Wars. Every. Single. Year. Learn more: https://greenmedinfo.com/blog/has-drug-driven-medicine-become-form-human-sacrifice

@sayerjigmi - Sayer Ji
In 2013, the National Cancer Institute admitted millions of "cancers" weren't cancer at all. 1.3 MILLION women unnecessarily treated for breast cancer over 30 years. The medical establishment's response? Crickets 🦗 Learn More: https://greenmedinfo.com/blog/30-years-breast-screening-13-million-wrongly-treated

@sayerjigmi - Sayer Ji
Meanwhile, peer-reviewed studies show: ✅Herniated discs spontaneously disappear ✅Gallstones rarely need surgery ✅Ear infections heal without antibiotics ✅Light therapy beats acne drugs ✅Breathing techniques match antidepressants Your body knows how to heal. Even some cases of breast cancer can regress spontaneously. Learn more: https://greenmedinfo.com/blog/yes-breast-cancer-can-and-often-does-spontaneously-regress-confirmed-case-reports1

@sayerjigmi - Sayer Ji
The cancer industry generates $156 BILLION annually. Every mammogram → biopsy → surgery cascade = $73,200 Watchful waiting = $0 When doing nothing pays nothing, guess what they recommend? Learn more about the dark side of BCAM: https://greenmedinfo.com/blog/covering-causes-breast-cancer-1985-astrazenecas-bcam-2

@sayerjigmi - Sayer Ji
Your body is a 50-trillion-cell quantum symphony that's been perfecting itself for 3.8 billion years. Maybe—just maybe—it knows more about healing than a system that profits from disease. Read the full paradigm-shifting piece: https://sayerji.substack.com/p/do-nothing-the-peer-reviewed-prescription


@sayerjigmi - Sayer Ji
🚨Four Years of Lawfare and Black Ops: The Silence Ends Here After 4 years of being stalked, smeared, and silenced through covert black ops and weaponized legal warfare — I’m finally telling the full story. They tried to destroy my life. They failed. Here’s what you weren’t supposed to see: 🧵 🔗 https://sayerji.substack.com/p/four-years-of-lawfare-and-black-ops

@sayerjigmi - Sayer Ji
🧨 For 4 years, my family and I were digitally tracked and hunted. Not by criminals — but by institutions. Legal threats. Vexatious lawsuits directed at family. Entrapments. Black bag tactics. Because I spoke inconvenient truths. They weaponized the system against me and my loved ones. Here is one very public example, they leaked (sadly, there are more they managed to keep secret, but not for long): Brian Rothschild (@USCLawers) and his Center for Countering Digital Hate linked network orchestrated a coordinated black operation threatening a mass wrongful death lawsuit against me, and others on the "disinformation dozen" list including now HHS Secretary @RobertKennedyJr. 📎
@sayerjigmi - Sayer Ji
🛰️Behind closed doors, taxpayer dollars and private interests were funneled into one of the most insidious psy-ops in recent history — a campaign to silence truth-tellers through deception, disruption, and digital warfare, in a globally coordinated attempt to re-enact Colonial era seditious libel laws. Leveraging transatlantic intelligence networks, they surveilled, distorted, and targeted citizens exercising their constitutionally protected speech — all under the cloak of plausible deniability. This wasn’t just legal intimidation. This was covert warfare. This was a hit job. Dive deeper into what they did, and are still doing to truth-tellers.... 1️⃣ International Governments Are Criminalizing Free Speech Through Global Coordination 🔍 New files expose the plot to suppress dissent worldwide — not through dialogue, but through censorship, surveillance, and coercion. 📖 Read the exposé: 👉 https://tinyurl.com/crimefreespeech 2️⃣ CCDH CEO Imran Ahmed Orders “Black Ops” Against RFK Jr. in Shocking Memo Leak 🕵️♂️ Newly leaked documents reveal direct coordination to sabotage a U.S. presidential candidate using covert psychological and reputational warfare. 📖 Full story here: 👉 https://greenmedinfo.com/content/exposed-ccdh-ceo-imran-ahmed-orders-black-ops-against-rfk-jr-shocking-memo-lea


@sayerjigmi - Sayer Ji
🚨Why was I made a target? Because I spoke inconvenient truths. About pharma. About lockdowns. About sovereignty. And because my work advocating at http://www.Greenmedinfo.com and http://www.StandforHealthFreedom.com for natural health and bodily sovereignty over the past 20 years reached hundreds of millions. We didn’t just question the narrative — We exposed it. And provided the public information on safe alternatives. We also warned people early about the deadly risks of the mRNA injections. And the feedback we’ve received confirms what we knew all along: Our work saved lives. Here’s one example they didn’t want you to see, released in late 2020: 📎 FDA documents reveal post-jab death & 21 serious conditions https://greenmedinfo.com/blog/covid-19-vaccine-bombshell-fda-documents-reveal-death-21-serious-conditions-possi1


@sayerjigmi - Sayer Ji
👁️🗨️ This wasn’t just about me. I was just targeted to be made an example and to intimidate others. Countless others faced similar attacks — healers, journalists, scientists, mothers, even lawyers. This is systemic. We were in an era of digital McCarthyism. They don’t need to burn books when they can shadowban your life.
@sayerjigmi - Sayer Ji
🕊️ But here’s what they didn’t expect: That I would survive. That I would tell the story. That I would rise with allies, more aligned, more focused — and more determined than ever. This isn’t just a memoir. It’s a warning. And an invitation.
@sayerjigmi - Sayer Ji
📖 Read the full exposé: ➡️ https://sayerji.substack.com/p/four-years-of-lawfare-and-black-ops 🎙️ This is for every truth-teller who has been silenced, gaslit, or exiled. 💡 This is about reclaiming narrative sovereignty.

@sayerjigmi - Sayer Ji
🕊️ If you’ve endured the last four years with your eyes open, your heart broken, and your voice intact — you are not alone. A global shift is underway. The age of silencing is giving way to the age of sovereignty, truth, and regenerative freedom. If you're ready to transform pain into purpose — If you're building the new while walking away from the broken — Join us. 🌍 The Global Wellness Forum is calling: A sanctuary for sovereign thinkers, healers, creators, and protectors of life. → http://www.globalwellnessforum.org @G_W_Forum


@sayerjigmi - Sayer Ji
🚨 Surgical Betrayal? Removing Tonsils & Adenoids Increases Risk of 28 Diseases! 🚨 Parents, have you been told that removing your child’s tonsils or adenoids is no big deal? A shocking study reveals these “routine” surgeries increase the risk of 28 diseases! 🧵 The hidden dangers doctors aren’t telling you... 👇
@sayerjigmi - Sayer Ji
1/ Tonsillectomies & adenoidectomies are among the most common childhood surgeries. Doctors often recommend them for: ✅ Frequent throat infections ✅ Sleep apnea ✅ Breathing issues But what if these procedures do far more harm than good? 😨
@sayerjigmi - Sayer Ji
2/ A massive study published in JAMA Otolaryngology analyzed 1.2 million children over 30 years. The results are shocking—children who had their tonsils or adenoids removed faced significantly higher risks of disease later in life! 📑Read the JAMA article here: https://watermark.silverchair.com/jamaotolaryngology_byars_2018_oi_180026.pdf
@sayerjigmi - Sayer Ji
3/ Here’s what they discovered: 🔴 Removing tonsils = 2-3X higher risk of respiratory infections (pneumonia, bronchitis, COPD). 🔴 Removing adenoids = 17% higher risk of allergic conditions (asthma, eczema, conjunctivitis). 🔴 Both surgeries = Higher lifetime disease risk.
@sayerjigmi - Sayer Ji
4/ Wait… aren't these surgeries supposed to prevent infections? 🤔 Yes, they may reduce throat infections short-term, but at a huge cost—weakening the immune system & increasing disease risks over a lifetime.
@sayerjigmi - Sayer Ji
5/🚨 Why is this happening? Tonsils & adenoids aren’t useless tissues! They’re powerful immune organs, filtering out pathogens before they reach the lungs. Removing them cripples the immune system. 👇This is a picture of me as a mostly sick child, whose adenoids were removed when I was only 6. I had a lifetime of respiratory issues, infections, and related health issues. Were they related? I wonder if I could have avoided a lifetime of suffering had they left my adenoids intact?
@sayerjigmi - Sayer Ji
6/ Think of your tonsils & adenoids like a security checkpoint for your body. 🛑 Tonsils = Detect and trap harmful invaders. 🛑 Adenoids = Boost immune response, especially in early life. Surgically removing them is like dismantling your body's natural defense system. 🥼Doctors claim these surgeries are “routine” & “safe.” But do they ever tell you about the lifelong consequences? Here’s what kids may face: ❌ More lung diseases (COPD, bronchitis) ❌ Increased risk of asthma & allergies ❌ Greater vulnerability to infections
@sayerjigmi - Sayer Ji
8/ 💡 The big question: Are these surgeries truly necessary? In many cases, the answer is NO. Parents are rarely given safer alternatives, such as: ✅ Strengthening immunity through diet & probiotics ✅ Addressing underlying causes (e.g., food intolerances, gut health) ✅ Natural anti-inflammatory treatments 🌱If you are interested in natural alternatives, I created an entire database of over 100,000 studies covering natural approaches to hundreds of ailments called http://www.Greenmedinfo.com, which is free to use.

@sayerjigmi - Sayer Ji
9/ We need to rethink the way pediatric medicine approaches these surgeries. Modern medicine prioritizes quick fixes—but ignores long-term consequences. It’s time to challenge the system & demand safer, holistic solutions. 🌱 Before considering surgery for your child, ask: ❓ Is this truly necessary? ❓ What are the long-term risks? ❓ Have I explored natural alternatives? Doctors often push procedures without giving you all the facts. 👉Learn more about the study here: Removing Children's Tonsils and Adenoids Increases Risk for 28 Diseases, Study Finds https://greenmedinfo.com/blog/removing-childrens-tonsils-and-adenoids-increases-risk-28-diseases-study-finds1


@sayerjigmi - Sayer Ji
🚨 BREAKING: The UK Just Ordered Apple to Kill Encryption for 2 Billion People—And They Can’t Even Talk About It 🚨 A global privacy nightmare is unfolding. The UK government secretly ordered Apple to backdoor encrypted iCloud storage worldwide—but Apple is legally forbidden from revealing this order, or they face criminal charges. This affects 2 BILLION USERS. Here’s the full story & why it’s part of a much bigger power grab. 🧵👇
@sayerjigmi - Sayer Ji
1/ Under the UK’s Investigatory Powers Act (IPA) 2016, Apple was served a Technical Capability Notice (TCN)—forcing them to create a backdoor for encrypted iCloud data. This is not limited to UK users. It applies worldwide, meaning your private files are at risk, no matter where you live. 🔗@macworld report: https://www.macworld.com/article/2602513/uk-demands-backdoor-to-apples-encrypted-cloud-storage-putting-everyone-at-risk.html

@sayerjigmi - Sayer Ji
2/ Apple is legally forbidden from revealing this order. If Apple even acknowledges that the UK issued this demand, they could face criminal charges. This is a secret government order with global consequences.
@sayerjigmi - Sayer Ji
3/ This isn’t just about the UK (although they are leading the charge in threatening citizens in OTHER countries for violating BRITISH censorship laws!) If Apple complies, every government in the world will demand the same access—from the US to China to authoritarian regimes. End-to-end encryption would be effectively dead.
@sayerjigmi - Sayer Ji
4/ Apple’s Choice: 🔓 Comply & weaken encryption globally 🚪 Refuse & withdraw services from the UK WhatsApp & Signal faced similar threats last year and vowed to leave the UK rather than compromise security. Will Apple do the same? 🚨Watch the heated discussion between Damian Collins, director of CCDH (architect of the UK Online Safety Bill), and Signal’s CEO: https://www.youtube.com/watch?v=E--bVV_eQR0
@sayerjigmi - Sayer Ji
5/ Why This Matters: ☑️Encryption protects financial data, health records, personal security (e.g. where you live or work), and private conversations. ☑️Governments always say they need backdoors for national security—but history shows they’re used for mass surveillance. ☑️Once a backdoor exists, hackers, rogue employees, and other governments WILL find it.
@sayerjigmi - Sayer Ji
6/ The UK is trying to dominate the global surveillance & censorship landscape. The UK is part of Five Eyes (UK, US, Canada, Australia, NZ), but notably, the US, Canada, Australia, and New Zealand have supported strong encryption to mitigate cyber threats. Yet, the UK stands alone in its war on encryption.
@sayerjigmi - Sayer Ji
7/ The Free Speech Crackdown 🛑 This isn’t just about encryption—it’s about control. Governments worldwide are criminalizing dissent and censoring free speech, using tech companies as their enforcement arms. 🔗 GreenMedInfo Report: https://greenmedinfo.com/content/breaking-international-governments-are-criminalizing-free-speech-through-glo-3

@sayerjigmi - Sayer Ji
8/ This ties into the UK’s broader, GLOBALLY ORCHESTATED censorship agenda: ⚠️ The Online Safety Bill criminalizes encrypted messaging & forces platforms to scan private messages. ⚠️ The Digital Services Act (EU) gives governments the power to shut down online content they don’t like. ⚠️ Leaked US-UK documents show direct coordination between UK intelligence & the Biden administration to censor online speech: 🚨Learn more about the global plot to adjudicate and criminalize free speech involving bilateral engagement with 20+ countries, and coordination with NATO and the G7: https://greenmedinfo.com/content/america-first-legal-obtains-new-internal-cdc-documents-revealing-foreign-collu (@America1stLegal's CDC lawsuit revealed this plot)

@sayerjigmi - Sayer Ji
9/ Meet the architects of speech policing: CCDH 🕵️♂️ The Center for Countering Digital Hate (CCDH)—a UK intelligence-backed group—has been a driving force behind global censorship. They were caught: 🔥 Running “black ops” to suppress RFK Jr.’s presidential campaign. 🔥 Leading the "Kill Musk’s Twitter" directive, trying to shut down free speech on X. 🔥 Labeling 12 private US citizens as the “Disinformation Dozen” to justify mass censorship. 🔗 Reclaim the Net Investigation: https://reclaimthenet.org/black-ops-how-a-us-uk-censorship-group-targeted-rfk-jr-to-stifle-dissent The same UK group behind mass censorship also helped design the UK’s anti-encryption policies via the UK Online Safety Bill passed in 2024.

@sayerjigmi - Sayer Ji
10/ The Pattern is Clear: 1️⃣ Governments create "safety" laws to justify surveillance. 2️⃣ They pressure tech companies to enforce censorship. 3️⃣ Once encrypted services are gone, nothing is private anymore. This is the biggest attack on digital freedom in history. And most recently @elonmusk and @lindayaX appear to have taken the bait by backing the Kids Online Safety Bill (KOSA) - a 'child safety' bill trojan horse for draconian censorship: https://sayerji.substack.com/p/alert-elon-musk-endorses-ccdh-backed?utm_source=publication-search

@sayerjigmi - Sayer Ji
11/ What Can We Do? 🔹 Support companies that refuse to build backdoors (Signal, ProtonMail, etc.). 🔹 Push for legislation that protects encryption & free speech. 🔹 Stay informed & spread awareness—governments count on secrecy to push these policies through. 🔹 Follow and support privacy and internet freedom organizations such as: @G_W_Forum @FFO_Freedom @ReclaimTheNetHQ @standforhealth1 @ChildrensHD @brownstoneinst @anhcampaign @FreeWCH @TheNHF
@sayerjigmi - Sayer Ji
12/ This is the ultimate power grab: controlling all digital communication. If Apple caves, every other platform will be forced to follow. 📌 The UK’s Global Playbook: 🔹 A backdoor to encryption (Investigatory Powers Act). 🔹 A government-linked censorship network (CCDH). 🔹 A speech-policing framework that extends worldwide (Online Safety Bill). This is a global effort to control what people can say, share, and store privately.
@sayerjigmi - Sayer Ji
13/ Final Warning: This is bigger than Apple. It’s about the future of free expression, privacy, and online autonomy. 📣 We are at a crossroads: If we don’t fight back, encryption is gone. If we don’t push back, speech is controlled. This is the modern battle for digital freedom. Support independent journalists like @VigilantFox @TheChiefNerd @KanekoaTheGreat @HealthRanger @zeee_media @newstart_2024 @RenzTom and spread the word!

@sayerjigmi - Sayer Ji
🚨 The Shocking Truth About Polio and Its Disappearance 🚨 What if everything we thought we knew about polio and vaccines was wrong? Dive into the untold story that challenges the foundations of public health. 🧵👇
@sayerjigmi - Sayer Ji
1/ Where did polio go? 🤔 The "disappearance" of polio coincided with the reclassification of paralytic conditions into new categories like Acute Flaccid Paralysis (AFP) and Guillain-Barré Syndrome (GBS). Was this a redefinition, not eradication? View the extensive analysis and evidence by reading: "The "Disappearance" of Polio": https://greenmedinfo.com/blog/disappearance-polio

@sayerjigmi - Sayer Ji
2/ At the same time, DDT☠️ and other toxic pesticides—linked to paralysis—were being banned. Could polio have been a symptom of industrial toxicity rather than just a presumably infectious virus? 🌿 More details at: "Everything You Learned About the Cause of Polio is Wrong" https://greenmedinfo.com/blog/everything-you-learned-about-cause-polio-wrong

@sayerjigmi - Sayer Ji
3/ The oral polio vaccine (OPV), meant to save lives, introduced new epidemics. Vaccine-derived poliovirus (VDPV) is now a leading cause of paralysis worldwide. We replaced one problem with another. 🚨 ‼️Example: The Cutter Incident of 1955 involved a batch of improperly inactivated polio vaccine from Cutter Laboratories, which led to approximately 40,000 cases of vaccine-induced poliomyelitis, causing widespread public concern and scrutiny of vaccine safety protocols. More details: https://pmc.ncbi.nlm.nih.gov/articles/PMC1383764/ More info on how the original polio vaccines caused polio paralysis: "Polio Vaccines Now The #1 Cause of Polio Paralysis" https://greenmedinfo.com/blog/polio-vaccines-now-1-cause-polio-paralysis


@sayerjigmi - Sayer Ji
4/ India’s "polio-free" status hides a dark truth: 491,000 cases of NPAFP (non-polio acute flaccid paralysis) caused by the vaccine. These cases were 2x as deadly as wild polio. 💔 Read "India's Polio-Free Status a Cruel Joke": https://greenmedinfo.com/blog/indias-polio-free-status-cruel-joke

@sayerjigmi - Sayer Ji
5/ The connection to HIV/AIDS is chilling. Contaminated polio vaccines, developed using monkey kidneys, may have seeded the zoonotic transfer of HIV into humans. A catastrophic cost for "progress." 🩸 Learn more by reading "What Really Caused The AIDS Epidemic?" https://greenmedinfo.com/blog/what-really-caused-aids-epidemic

@sayerjigmi - Sayer Ji
6/ Early polio vaccines were also tainted with SV40, a cancer-causing virus. The CDC’s mysterious removal of their webpage linking SV40 to polio vaccines raises red flags. What else are we not being told? 🕵️ Read "CDC 'Disappears’ Page Linking Polio Vaccines To Cancer-Causing Viruses"https://greenmedinfo.com/blog/cdc-disappears%E2%80%99-page-linking-polio-vaccines-cancer-causing-viruses1 Learn more about SV-40 on http://GreenMedInfo.com's database on the topic: https://greenmedinfo.com/disease/simian-virus-40-sv40



@sayerjigmi - Sayer Ji
7/ Even the so-called eradication of polio may be a statistical mirage. Cases of AFP surged as "polio" diagnoses vanished. Are we being gaslit by reclassification? 🔥 Learn more by reading "The "Disappearance" of Polio" by Dr. Suzanne Humphries : https://greenmedinfo.com/blog/disappearance-polio

@sayerjigmi - Sayer Ji
9/ The narrative of polio’s disappearance isn’t one of triumph—it’s one of complexity, cover-ups, and shifting definitions. Vaccines became a Trojan Horse, spreading new diseases while masking old ones. ⚠️ Learn more by reading: "The Failure of Global Polio Eradication": https://greenmedinfo.com/blog/failure-global-polio-eradicatio

@sayerjigmi - Sayer Ji
10/ Even the Dalai Lama, a global symbol of compassion, has endorsed and personally gave oral polio vaccines to children in India. But would Buddha advocate for medical mandates, or interventions with unintended, adverse effects without properly informing parents? 🧘♂️💉 Buddhist principles of non-violence and respect for individual suffering invite us to question coercive, and potentially crippling medical interventions. 🌏 Learn more by reading: "Questioning The Dalai Lama: Who Would The Buddha Vaccinate?" https://greenmedinfo.com/blog/questioning-dalai-lama-who-would-buddha-vaccinate1

@sayerjigmi - Sayer Ji
11/ It’s time to demand answers. How many lives have been altered by misguided campaigns? Why are critical links between toxins/toxicants, vaccines, and health ignored? The truth matters. 💡 Let’s start asking the hard questions. What’s your take? Let’s discuss.👇 #Polio #Vaccines #HealthTruth If you are critical thinker who cares about your health and those of your loved ones, join our free newsletter: Greenmedinfo.com/newsletter and use our free resource enjoyed by millions around the world: http://www.Greenmedinfo.com


@sayerjigmi - Sayer Ji
🔥 “ELECTION INTERFERENCE!!” Musk Exposes Labour’s Secret U.S. Meddling 🚨 UK Labour accuses Elon Musk of undermining British democracy. But what if the real story is THEIR meddling in U.S. elections? 💥 Black ops, FEC complaints, and a crackdown on free speech—it’s a diplomatic bombshell with global implications. Here’s the full story 🧵
@sayerjigmi - Sayer Ji
1/ Labour’s Accusations Against Musk 🇬🇧 In a viral post shared by Elon, Labour MP Barry Gardiner accused Musk of “undermining democracy”, claiming his criticism of the UK government was an attack on a “recently, democratically elected government.” But the allegations quickly turned back on Labour… 👇
@sayerjigmi - Sayer Ji
2/ Musk Fires Back via Matt Goodwin Political analyst @GoodwinMJ called out Labour’s hypocrisy: “Barry, you belong to a party that sent activists to America to actively plot to, and I quote, ‘kill Elon Musk’s Twitter.’" Goodwin also highlighted Labour’s history of attacking Musk, Trump, and other dissenters. 🔗More details here: https://sayerji.substack.com/p/crossfire-of-democracy-uk-labour

@sayerjigmi - Sayer Ji
3/ Labour’s U.S. Election Meddling 🇺🇸 Sofia Patel, Labour’s Head of Operations, was caught on LinkedIn coordinating activists to campaign for Harris-Walz in U.S. battleground states: ❗️Nearly 100 volunteers recruited. ❗️Housing & logistics arranged. As a result, Trump filed an FEC complaint, alleging illegal foreign contributions. 📖 Read more: bbc.com/news/articles/…
@sayerjigmi - Sayer Ji
4/ The CCDH Connection 🌍 Labour’s ties to the Center for Countering Digital Hate (CCDH) deepen the scandal: ❗️CCDH ran “black ops” targeting RFK Jr. and Elon Musk, aiming to suppress their influence and silence dissent. https://greenmedinfo.com/content/exposed-ccdh-ceo-imran-ahmed-orders-black-ops-against-rfk-jr-shocking-memo-lea ❗️Leaked directive: “Kill Musk’s Twitter” aimed to silence dissent and trigger U.S. & EU regulatory action. https://greenmedinfo.com/content/breaking-kill-musks-twitter-leaked-docs-reveal-british-advisors-kamala-harris- 🚨Morgan McSweeney, founder of CCDH, adds another layer of controversy: McSweeney is not only tied to CCDH but also served as key advisers to both Keir Starmer and Kamala Harris’s campaign, creating potential conflicts of interest that fuel allegations of coordinated interference. This web of influence reveals CCDH as more than just an NGO—it’s a political weapon for suppressing opposition and shaping narratives globally.


@sayerjigmi - Sayer Ji
5/ 🚨But Labour Interferes in Their OWN Elections Too The hypocrisy is staggering: while accusing Musk of meddling, Labour-linked groups like CCDH and Hope Not Hate (HNH) have interfered in UK elections: ⁉️Susan Hall’s Mayoral Race: CCDH’s sister NGO, HNH, received funding from the UK’s Counter Extremism Unit, which was used to target Hall. NHN, the same NGO who UK grooming rape gang whistleblower @TRobinsonNewEra exposed, a British taxpayer-funded, government-directed NGO openly took credit for stealing her election chances as detailed below. These groups manipulate elections under the guise of combating "extremism" while crushing dissent. 🧩 Shared Staff: Jemma Levene, former Deputy Director of HNH, is now COO at CCDH. 📖 Full details from @CharlotteCGill : https://www.charlottecgill.co.uk/p/who-funds-you-hope-not-hate-case

@sayerjigmi - Sayer Ji
6/ Dark Money Funders 💰 CCDH and HNH act as proxies for government influence, using funds from: 💵Paul Hamlyn Foundation 💵Burrow Cadbury Trust 💵Rowntree Charitable Trust These organizations export their playbook globally, from targeting Cindy Hall in the UK to running black ops against RFK Jr. (the "disinfo dozen") and Musk in the U.S. In fact, leaked documents obtained via an @America1stLegal FOIA request reveal that as early as 2021, the Biden-Harris administration received a “masterclass” in censorship from the UK’s Countering Disinformation Unit (CDU); an interagency meeting which included discussing censoring election-related content, and which promoted a leftist, "woke" dogma. 🇬🇧 This shocking collaboration shows that the UK’s meddling in U.S. democratic institutions has been happening long before the recent election interference controversy surfaced. 📖 Learn more about this troubling, globally coordinated foreign influence operation attempting to censor, adjudicate and criminalize all free speech online: https://greenmedinfo.com/content/america-first-legal-obtains-new-internal-cdc-documents-revealing-foreign-collu 👉Learn more about CCDH's Funders: https://greenmedinfo.com/content/17-dark-money-funders-behind-ccdhs-kill-elon-s-twitter-directive1


@sayerjigmi - Sayer Ji
7/ EO 13848 + U.S. Laws UK's Labour Party May Have Violated ⚖️ 1️⃣ EO 13848 (Executive Order 13848): ✅Signed in 2018 to address foreign interference in U.S. elections after allegations of Russian meddling in 2016. It targets any foreign entity attempting to: 🚨Undermine public confidence in elections. 🚨Manipulate outcomes through covert or overt means (e.g., disinformation or logistical support). 🚨Violators can face asset freezes, sanctions, and more. ✅Labour’s coordinated campaigns and CCDH’s black ops could fall squarely under this order’s provisions. 2️⃣ FARA (Foreign Agents Registration Act): ✅Requires foreign entities or individuals working to influence U.S. politics on behalf of a foreign principal to register with the DOJ. 🚨Labour’s U.S.-based operations, including activist deployment and links to CCDH, could violate this act if unregistered. ❗️Penalties: Fines, prison, or forced disclosure of all activities and funding sources. 3️⃣ FECA (Federal Election Campaign Act) ✅Prohibits foreign nationals from contributing to U.S. elections, whether financially or through in-kind contributions like housing and logistics. 🚨Sofia Patel’s alleged coordination of activists to assist Harris-Walz in battleground states could breach FECA if Labour provided any form of support. These laws exist to protect U.S. democracy from foreign manipulation. Labour’s actions, if proven, may trigger serious consequences. 🔗Read Trump's complaint against the UK: https://greenmedinfo.com/content/re-complaint-against-labour-party-united-kingdom-and-harris-president

@sayerjigmi - Sayer Ji
8/ Hypocrisy Exposed 🤔 While Labour accuses Musk of meddling in UK democracy, their alleged actions in the U.S.—sending activists, suppressing speech, and coordinating with CCDH—show a troubling pattern of interference. Who is really undermining democracy?
@sayerjigmi - Sayer Ji
9/ Musk Calls Out ‘ELECTION INTERFERENCE!!’ 💥 @elonmusk has publicly blasted Labour, CCDH, and their allies, accusing them of orchestrating attacks on free speech and election integrity—not just in the UK, but in the US as well! The UK’s Online Safety Bill is so tyrannical it could allow Britain to prosecute U.S. citizens for violating their speech laws, effectively reviving “seditious libel laws” against a former colony. This isn’t just hypocrisy—it’s a diplomatic crisis. Elon Musk’s fight for free speech may be the last line of defense for countries where freedoms are being systematically eroded. If speech is silenced everywhere else, platforms like X remain a beacon of hope. 🔥Learn more by reading: The 'Kill Musk’s Twitter' Directive: A Modern 1776 Stand Against a Global Plot for Censorship and Election Interference https://greenmedinfo.com/content/kill-musk-s-twitter-directive-modern-1776-stand-against-global-plot-censorship2 #ElectionInterference #FreeSpeech #Musk #UKLabour #CCDH #DiplomaticCrisis

@sayerjigmi - Sayer Ji
10/ Wrapping Up 🚨🇺🇸🇬🇧 As Trump’s campaign gains momentum, his FEC complaint against Labour awaits action—and if re-elected, he’s likely to pursue justice for these alleged foreign interference acts. Meanwhile, Elon faces growing pressure, with the EU Commission being urged to act over his so-called “election meddling.” What’s at Stake? 🗣️ Free Speech: CCDH’s campaigns threaten global discourse. 🗳️ Election Integrity: Labour’s actions undermine democracy. 🇺🇸🇬🇧 U.S.-UK Relations: These tensions could fracture transatlantic ties. What’s Next? Labour and CCDH must come clean. A public apology and reset may be their only way to avoid further fallout. Will they own up—or double down? #ElectionInterference #FreeSpeech #Musk #Trump #UKLabour #CCDH